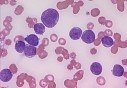

Traversée sur le Tariq Ibn Ziyad : L’ENTMV à la rescousse de la SNCM
Traversée sur le Tariq Ibn Ziyad : L’ENTMV à la rescousse de la SNCM
-
 Santé
25-07-2022 | 15:29
Santé
25-07-2022 | 15:29Politique de la santé : Révision des statuts du secteur à la prochaine rentrée sociale
-
 Santé
25-07-2022 | 15:25
Santé
25-07-2022 | 15:25Canicule : Le ministère de la Santé rappelle les précautions à observer
-
 Santé
25-07-2022 | 14:50
Santé
25-07-2022 | 14:50Contre les maladies cardiovasculaires, mangez du chocolat noir
-
 Santé
25-07-2022 | 14:48
Santé
25-07-2022 | 14:48Cancer : la génétique est un plus gros facteur de risque que le mode de vie
-
 Santé
25-07-2022 | 14:46
Santé
25-07-2022 | 14:46Le stress précoce déteint à vie sur le cerveau
-
 Santé
25-07-2022 | 14:45
Santé
25-07-2022 | 14:45Vers un nouveau traitement prometteur ?
-
 Santé
25-07-2022 | 14:41
Santé
25-07-2022 | 14:41Le vieillissement des cellules, une piste de traitement
-
Santé
25-07-2022 | 14:39
Santé
25-07-2022 | 14:39Leucémie myéloïde : Une maladie maîtrisée à 90%
-
 Santé
24-07-2022 | 18:09
Santé
24-07-2022 | 18:09bilan de la pandemie du covid-19 : 67 nouveaux cas et aucun décès
Flux RSS DKNEWS-DZ.COM

LES FLASH ACTU
-
10:37 05-01-2016Le point de l'actualité nationale
-
10:35 05-01-2016Le point de l'actualité internationale
-
10:34 05-01-2016Les marchés mondiaux débutent 2016 en recul à cause de la Chine et des tensions géopolitiques
-
15:41 04-01-2016Le pétrole en petite hausse, aidé par les tensions entre Téhéran et Ryadh
TOUTES LES NEWS
-
Coronavirus : 4 nouveaux cas et aucun décès
Quatre (4) nouveau cas de coronavirus (Covid-19) ont été enregistrés, et aucun décès n'a été déploré, alors que deux (2) guérisons ont été recensées ces dernières 24 heures en Algérie, indique mercredi le ministère de la Santé dans un comm..
-
PANDEMIE DE COVID-19 Etats-Unis : environ 26.000 cas d'infection signalés chez les enfants en une semaine
Environ 26.000 cas de COVID-19 chez les enfants ont été signalés aux Etats-Unis au cours de la semaine se terminant le 12 janvier, selon le dernier rapport de l'Académie américaine de pédi..
-
Khenchela : L'hôpital de Kaïs doté d'un appareil d'IRM
Le service de radiologie de l'établissement public hospitalier de Kaïs (wilaya de Khenchela) a été doté d'un appareil d'imagerie par résonance magnétique (IRM), a-t-on appris mardi aup..
-
Oran : Nouveau programme thérapeutique pour la prise en charge des diabétiques de type 1
Le service d’endocrinologie de l’EHU "1er novembre" d’Oran a entamé un nouveau programme thérapeutique pour la prise en charge des diabétiques de type1, a-t-on appris, dimanche, de la cell..
-
Les aliments pour booster votre immunité
En période de diffusion des virus, il est essentiel de dynamiser l'organisme pour booster les défenses immunitaires. En pratique, on met l'accent sur les nutriments qui soutiennent l'action des globules blancs et des anticorps.
-
Le chocolat noir a des effets positifs sur le stress, la mémoire et l'immunité
Deux nouvelles études, prouvant les bienfaits du chocolat noir, viennent d'être présentées au public. Il aurait des effets bénéfiques sur le stress, l'inflammation, l'humeur, la mémoire et l'immunité.
-
système immunitaire : Comment il fonctionne en 9 vrai/faux
Le retour de l'automne, accompagné parfois de fatigue et de stress, fragilise nos défenses immunitaires. Sans compter que la vie avec le Covid-19 les met aussi à rude épreuve. Alors on révise nos connai..
-
BILAN DE LA PANDEMIE DU COVID-19 : Cinq nouveaux cas et aucun décès
Cinq (05) nouveaux cas de coronavirus (Covid-19) et aucun décès n'ont été enregistrés, alors que quatre (04) guérisons ont été recensée ces dernières 24 heures en Algérie, à indiquer hier le mini..
L'EDITO
Le Président de la République, Abdelaziz Bouteflika, a reçu hier le Premier ministre français, Jean-Marc Ayrault, en visite officielle en Algérie. L'audience s'est déroulée en présence du Premier ministre, Abdelmalek Sellal. Lors de cette audience...
LIRE LA SUITEPHOTOS & VIDEOS
-
LE FORUM 14-04-2014 | 15:41Mr Abdelaziz Belkhadem au Forum de DK News 14/04/2014
CHRONIQUES
-
 Walid B
Walid B
Grâce à des efforts inlassablement consentis et à une efficacité fièrement retrouvée, la diplomatie algérienne, sous l’impulsion de celui qui fut son artisan principal, en l’occurrence le président de la République Abdelaziz Bouteflika, occupe aujour
-
 Boualem Branki
Boualem Branki
La loi de finances 2016 n’est pas austère. Contrairement à ce qui a été pronostiqué par ‘’les experts’’, le dernier Conseil des ministres, présidé par le Président Bouteflika, a adopté en réalité une loi de finances qui prend en compte autant le ress
-
 Walid B
Walid B
C'est dans le contexte d'un large mouvement de réformes sécuritaires et politiques, lancé en 2011, avec la levée de l'état d'urgence et la mise en chantier de plusieurs lois à portée politique, que ce processus sera couronné prochainement par le proj
-
 Boualem Branki
Boualem Branki
La solidité des institutions algériennes, la valorisation des acquis sociaux et leur développement, tels ont été les grands messages livrés hier lundi à Bechar par le ministre de l'Intérieur et des Collectivités locales Nouredine Bédoui.
-
 DK NEWS
DK NEWS
Le gouvernement ne semble pas connaître de répit en cette période estivale. Les ministres sont tous sur le terrain pour préparer la rentrée sociale qui interviendra début septembre prochain.
-
 Walid B
Walid B
Dans un contexte géopolitique régional et international marqué par des bouleversements de toutes sortes et des défis multiples, la consolidation du front interne s'impose comme unique voie pour faire face à toutes les menaces internes..
-
 Walid B
Walid B
Après le Sud, le premier ministre Abdelmalek Sellal met le cap sur l'Ouest du pays où il est attendu aujourd'hui dans les wilayas d'Oran et de Mascara pour une visite de travail et d'inspection.









 MAMI : Au cœur d’une usine algérienne de production de boissons gazeuses et de jus algériens
MAMI : Au cœur d’une usine algérienne de production de boissons gazeuses et de jus algériens  Laiterie Soumam : Les secrets d’une réussite
Laiterie Soumam : Les secrets d’une réussite  Lutte contre la drogue : Signature d’un accord entre le ministère des Affaires religieuses et l’ONLDT
Lutte contre la drogue : Signature d’un accord entre le ministère des Affaires religieuses et l’ONLDT 

